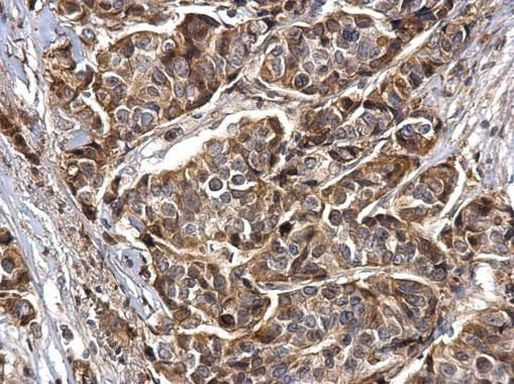
Synaptotagmin 1 Antibody in Immunohistochemistry (Paraffin) (IHC (P))

Search
Invitrogen
Synaptotagmin 1 Polyclonal Antibody
{{$productOrderCtrl.translations['antibody.pdp.commerceCard.promotion.promotions']}}
{{$productOrderCtrl.translations['antibody.pdp.commerceCard.promotion.viewpromo']}}
{{$productOrderCtrl.translations['antibody.pdp.commerceCard.promotion.promocode']}}: {{promo.promoCode}} {{promo.promoTitle}} {{promo.promoDescription}}. {{$productOrderCtrl.translations['antibody.pdp.commerceCard.promotion.learnmore']}}
产品信息
PA5-27935
已发表种属
宿主/亚型
分类
类型
抗原
偶联物
形式
浓度
规格
保存条件
运输条件
RRID
产品详细信息
Recommended positive controls: Synaptotagmin 1 tansfected 293T cell, mouse brain, rat brain.
Predicted reactivity: Mouse (100%), Rat (100%), Chicken (97%), Bovine (100%).
Store product as a concentrated solution. Centrifuge briefly prior to opening the vial.
靶标信息
Synaptotagmin 1 is a synaptic vesicle membrane glycoprotein that is widely expressed throughout the CNS and is generally thought to act as the Ca2+ sensor in the regulation of exocytosis and neurotransmitter release. Studies indicate that synaptotagmin's Ca2+ mediated binding of SNAP25 is essential for the Ca2+ dependent triggering of membrane. It has been demonstrated that discrete residues within the c(2)b binding domain of synaptotagmin 1 independently specify endocytic rate and synaptic vesicle size. Synaptotagmin 1 may have a regulatory role in the membrane interactions during trafficking of synaptic vesicles at the active zone of the synapse. Further, Synaptotagmin 1 binds acidic phospholipids with a specificity that requires the presence of both an acidic head group and a diacyl backbone. A Ca(2+)-dependent interaction between synaptotagmin and putative receptors for activated protein kinase C has been reported. Synaptotagmin 1 can also bind to at least three additional proteins in a Ca(2+)-independent manner; these are neurexins, syntaxin and AP2. Diseases associated with the dysfunction of Synaptotagmin 1 include food-borne botulism and infant botulism.
⚠WARNING: This product can expose you to chemicals including mercury, which is known to the State of California to cause birth defects or other reproductive harm. For more information go to www.P65Warnings.ca.gov.
仅用于科研。不用于诊断过程。未经明确授权不得转售。